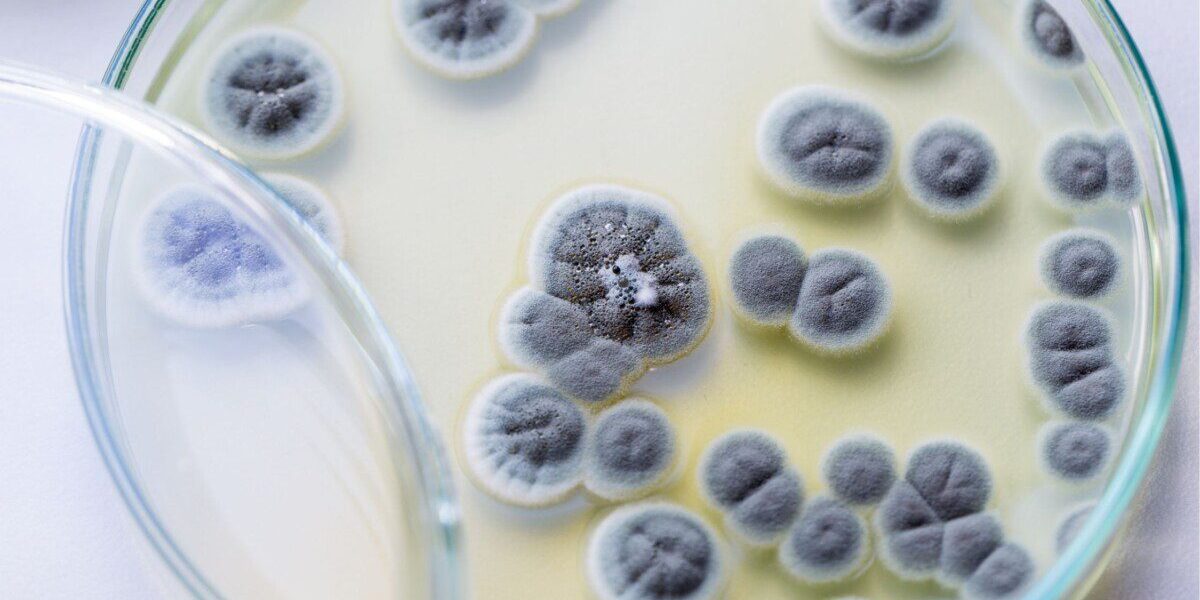

Take Mold Seriously Before This Happens
Mr. Dylan Michael nearly died from the effects of a toxic mold exposure. So many of our patients struggle with how many other health care providers have not taken their symptoms seriously. They go from specialist to specialist being told that their labs and tests are normal- “So don’t come back.” For the majority, thankfully, mold toxicity isn’t directly life-threatening, except in the sense that their suffering threatens their ability to live a normal life. In this news report, however, mold toxicity took that extra step.
In Plano, Texas in September of 2024, Mr. Michael was being a good grandson by cleaning his grandmothers ceiling, moldy as it was, but he ended up at death’s door a few weeks later. He finished the mold removal and thought little else until a few days later, despite some having fallen on him in the process. Then he got a light cough, something he thought would go away like any other cold. It continued, though, and 3 weeks later he started having heaviness in his chest.
After evaluation at an urgent care, they sent a sweating, clammy Mr. Michael to a hospital where he was placed on a ventilator and diagnosed with a double pneumonia. Soon after that, they realized he needed more than a ventilator: he needed ECMO, a machine that completely bypasses the lungs to put oxygen in and take carbon dioxide out of the blood. Without this, he would have likely died.
Now, before any thought arises of trying to raise excessive alarm, I will say that this is truly an unusual case. Very rarely does a mold exposure lead to a life-threatening illness, at least in this sense. However, we see so many suffering in their lives due to mold toxicity that has been missed, ignored, dismissed, and/or improperly treated. You may not be needing a ventilator, but if your life is disrupted by health issues that conventional medicine cannot explain, mold is on a list of root causes that we consider for our patients. Helping them restore healthier, more abundant lives means going beyond the conventional medical diagnoses, especially when those have already failed to find the issue. Patients deserve more than being told to just live with it (and take pharmaceuticals forever).
Original News:
Brown, L. (2024, September 13). Black mold exposure leaves Garland Man with life-threatening double pneumonia. Black mold exposure leaves Garland man with life-threatening double pneumonia. https://www.fox4news.com/news/dylan-michael-double-pneumonia-survivor-medical-city-plano-ecmo-treatment
Sanctuary Functional Medicine, under the direction of Dr Eric Potter, IFMCP MD, provides functional medicine services to Nashville, Middle Tennessee and beyond. We frequently treat patients from Kentucky, Alabama, Mississippi, Georgia, Ohio, Indiana, and more... offering the hope of healthier more abundant lives to those with chronic illness.

Dr. Eric Potter graduated from Vanderbilt Medical School and then went on to specialize in internal medicine (adult) and pediatric care, spending significant time and effort in growing his medical understanding while caring for patients from all walks of life.